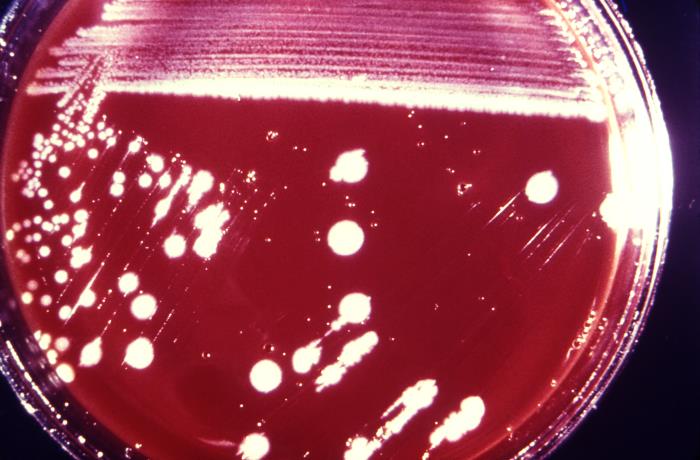
Colonias de Listeria monocytogenes. CDC Public Health Image Library (PHIL)

Listeria monocytogenes pertenece a la familia Listeriaceae. Se trata de un bacilo Gram positivo, con un tamaño de 0,5 - 2 x 0,5 micras, patógeno intracelular facultativo del sistema reticuloendotelial y móvil a temperaturas entre 20ºC y 25ºC.
En relación con su metabolismo, es anaerobio facultativo, catalasa positivo y oxidasa negativo.
Se distinguen 13 serotipos, siendo el 1/2a, el 1/2b y el 4b los principales causantes de enfermedades en humanos y animales.
Viabilidad, propagación y transmisión
Reservorio
Suelo, estiércol, materia vegetal en descomposición, lodos, agua, alimentos, humanos, bovinos, caprinos, ovinos, aves (pavos, gallinas, faisanes, palmípedos), peces, crustáceos.
Hospedadores
Humanos, bovinos, caprinos, ovinos, aves (pavos, gallinas, faisanes, palmípedos), peces, crustáceos.
Dosis Infectiva Mínima (DIM)
Puede encontrarse entre 10 y 108 unidades formadoras de colonias (ufc) en hospedadores sanos, y entre 0,1 y 106 ufc en hospedadores con elevado riesgo de infección.
Supervivencia ambiental
Sobrevive bien en suelo, agua, heces y alimentos. Es un microorganismo psicótrofo y de los más resistentes al calor, por lo que crece en un amplio rango de temperatura (entre -18ºC y 45ºC), en un amplio rango de pH (entre 3,3 y 9,6) y tolera concentraciones de sal del 20%.
Formas de resistencia
No presenta formas de resistencia.
Mecanismo de propagación y transmisión
La transmisión se produce principalmente a través de la ingesta de alimentos contaminados, como vegetales crudos, leche y derivados lácteos sin pasteurizar, carnes no cocinadas o poco cocinadas y algunos alimentos procesados (ciertos tipos de quesos blandos sin pasteurizar, carnes procesadas como fiambres, salchichas cocidas, patés, pescados y mariscos ahumados, entre otros).
Otros mecanismos de transmisión son el contacto directo con animales infectados o sus tejidos (zoonosis); por ejemplo, durante las labores de asistencia al parto, las necropsias o las tareas realizadas en mataderos, así como por contacto con excrementos de animales infectados, con materiales contaminados (p.ej. suelo) y por la inhalación de bioaerosoles.
Numerosos artrópodos, tales como las garrapatas y las moscas, son portadores de la bacteria y podrían actuar como vectores.
A excepción de la transmisión vertical, la transmisión de persona a persona es rara, pero no se puede descartar la transmisión nosocomial en las actividades sanitarias de obstetricia y ginecología.
Vías de entrada
Digestiva. Mucosas. Parenteral. Respiratoria.
Distribución geográfica
Mundial.
Efectos sobre la salud
Grupo de riesgo
2
(Ver Anexo II RD 664/1997 )Infección
Listeriosis: infección normalmente asintomática y de ocurrencia relativamente baja, presentando una mayor susceptibilidad los adultos de edad avanzada, los adultos inmunocomprometidos, las mujeres embarazadas, los fetos y los recién nacidos. La infección se puede manifestar de diversas formas, como las que se indican a continuación:
- Gastroenteritis febril aguda: forma no invasiva asociada a la ingesta de alimentos contaminados y que se caracteriza por síntomas tales como fiebre, cefaleas, náuseas, vómitos, dolor abdominal, diarrea y, en ocasiones, mialgias.
- Listeriosis local o cutánea: erupción cutánea caracterizada por la aparición de pápulas o pústulas en los brazos o en las manos, pudiendo acompañarse de fiebre, escalofríos, cefaleas, mialgias y dolor generalizado. Se ha asociado al contacto con animales infectados.
- Listeriosis óculo-glandular: síndrome febril agudo caracterizado por conjuntivitis e inflamación de los ganglios linfáticos delante de las orejas.
- Listeriosis del sistema nervioso central: complicación de la infección que puede presentarse en personas susceptibles, manifestándose principalmente como una meningitis o una meningoencefalitis, pudiendo en ocasiones producirse romboencefalitis.
- Listeriosis tifoidea: frecuente en personas inmunocomprometidas, se caracteriza por fiebre elevada.
- Otras formas: endocarditis, artritis, endoftalmitis, peritonitis derrames pleurales, abscesos internos y externos, etc.
En la mujer embarazada puede ser asintomática o manifestarse como una enfermedad similar a la gripe, con fiebre y otros síntomas inespecíficos tales como fatiga, escalofríos, cefaleas, dolor de espalda, artralgias, mareos ligeros o síntomas gastrointestinales.
Efectos alérgicos (Ver Anexo II RD 664/1997 ) / (Ver Allergen )
No se han descrito
Efectos tóxicos (Ver Anexo II RD 664/1997 )
No se han descrito
Efectos cancerígenos (Ver International Agency for Research On Cancer - IARC )
No se han descrito
Efectos en la maternidad
La transmisión se puede producir por vía transplacentaria, teniendo lugar la infección materna principalmente en el tercer trimestre, así como durante el parto (transmisión perinatal).
Si la transmisión se produce por vía transplacentaria, los daños en el feto pueden ser: aborto, muerte intrauterina (mortinato), parto prematuro o listeriosis neonatal de aparición temprana, que se manifiesta pocos días después del parto y puede dar lugar a neumonía, sepsis, meningitis o, en casos más graves, granulomatosis diseminada/infantiséptica.
Si la transmisión es perinatal, puede producirse una listeriosis neonatal de aparición tardía, mostrándose síntomas de meningitis una o varias semanas después del parto.
La tasa de mortalidad se encuentra en torno al 20%-30% (2) (12) (14).
Enfermedad
| CIE-10 | Nombre | Enfermedad de Declaración Obligatoria |
|---|---|---|
| A32 | Listeriosis | Sí |
Actividades laborales con riesgo
Clasificación Nacional de Actividades Económicas (CNAE)
| CNAE 2009 | Descripción |
|---|---|
| A0112 | Cultivo de arroz |
| A0141 | Explotación de ganado bovino para la producción de leche |
| A0142 | Explotación de otro ganado bovino y búfalos |
| A0143 | Explotación de caballos y otros equinos |
| A0144 | Explotación de camellos y otros camélidos |
| A0145 | Explotación de ganado ovino y caprino |
| A0146 | Explotación de ganado porcino |
| A0148 | Otras explotaciones de ganado |
| A0150 | Producción agrícola combinada con la producción ganadera |
| A0162 | Actividades de apoyo a la ganadería |
| A0170 | Caza, captura de animales y servicios relacionados |
| C1011 | Procesado y conservación de carne, excepto volatería |
| C1012 | Procesado y conservación de volatería |
| C1013 | Elaboración de productos cárnicos y de volatería |
| C1054 | Preparación de leche y otros productos lácteos |
| E3600 | Captación, depuración y distribución de agua |
| E3700 | Recogida y tratamiento de aguas residuales |
| F4322 | Fontanería, instalación de sistemas de calefacción y aire acondicionado |
| G4623 | Comercio al por mayor de animales vivos |
| G4632 | Comercio al por mayor de carne, productos cárnicos; pescado y productos del pescado |
| N7210 | Investigación y desarrollo experimental en ciencias naturales y técnicas |
| N7500 | Actividades veterinarias |
| O8123 | Otras actividades de limpieza |
| O8130 | Actividades de jardinería |
| R8610 | Actividades hospitalarias |
| R8621 | Actividades de medicina general y de medicina familiar y comunitaria |
| R8622 | Actividades de otras especialidades médicas |
| R8699 | Otras actividades sanitarias n.c.o.p. |
| S9141 | Actividades de los jardines botánicos y los parques zoológicos |
| S9311 | Gestión de instalaciones deportivas |
| S9329 | Actividades recreativas y de entretenimiento n.c.o.p. |
Clasificación Nacional de Ocupaciones (CNO)
| CNO 2011 | Descripción |
|---|---|
| 2112 | Otros médicos especialistas |
| 2121 | Enfermeros no especializados |
| 2123 | Matronos |
| 2130 | Veterinarios |
| 2210 | Profesores de universidades y otra enseñanza superior (excepto formación profesional) |
| 2421 | Biólogos, botánicos, zoólogos y afines |
| 3132 | Técnicos en instalaciones de tratamiento de residuos, de aguas y otros operadores en plantas similares |
| 3141 | Técnicos en ciencias biológicas (excepto en áreas sanitarias) |
| 3313 | Técnicos en anatomía patológica y citología |
| 3314 | Técnicos en laboratorio de diagnóstico clínico |
| 3327 | Ayudantes de veterinaria |
| 5611 | Auxiliares de enfermería hospitalaria |
| 5612 | Auxiliares de enfermería de atención primaria |
| 5893 | Cuidadores de animales y adiestradores |
| 5992 | Bañistas-socorristas |
| 6110 | Trabajadores cualificados en actividades agrícolas (excepto en huertas, invernaderos, viveros y jardines) |
| 6120 | Trabajadores cualificados en huertas, invernaderos, viveros y jardines |
| 6201 | Trabajadores cualificados en actividades ganaderas de vacuno |
| 6202 | Trabajadores cualificados en actividades ganaderas de ovino y caprino |
| 6203 | Trabajadores cualificados en actividades ganaderas de porcino |
| 6205 | Trabajadores cualificados en la avicultura y la cunicultura |
| 6209 | Trabajadores cualificados en actividades ganaderas no clasificados bajo otros epígrafes |
| 6430 | Trabajadores cualificados en actividades cinegéticas |
| 7250 | Mecánicos-instaladores de refrigeración y climatización |
| 7701 | Matarifes y trabajadores de las industrias cárnicas |
| 8160 | Operadores de máquinas para elaborar productos alimenticios, bebidas y tabaco |
| 9229 | Otro personal de limpieza |
| 9443 | Barrenderos y afines |
| 9511 | Peones agrícolas (excepto en huertas, invernaderos, viveros y jardines) |
| 9512 | Peones agrícolas en huertas, invernaderos, viveros y jardines |
| 9520 | Peones ganaderos |
| 9530 | Peones agropecuarios |
Prevención y control
Desinfectantes
Hipoclorito sódico al 1%, etanol al 70%, glutaraldehído, ácido peroxiacético, yodóforos, ozono.
Inactivación física
La inactivación se realiza con calor húmedo a 121ºC durante un mínimo de 15 minutos, con calor seco a 160ºC-170ºC durante 1 hora y con altas presiones (500 megapascales). Es sensible a la radiación ultravioleta de onda corta y a la radiación gamma. Normalmente se destruye durante la pasteurización y la cocción.
Antimicrobianos
Penicilina, amoxicilina, ampicilina, aminoglucósidos, trimetoprim-sulfametoxazol (TMP-SMX).
Vacunación
No disponible
Medidas preventivas generales
Vigilancia sanitaria y aislamiento de los animales infectados.
Destrucción de los cadáveres de los animales infectados, de los fetos abortados y de las placentas en condiciones de seguridad, según la normativa legal vigente.
En la industria alimentaria, adoptar buenas prácticas de higiene y seguridad alimentaria, cumpliendo con la normativa legal vigente.
Mantener los locales en condiciones adecuadas de ventilación, limpieza y desinfección.
Garantizar un adecuado mantenimiento, limpieza, desinfección y/o esterilización de as herramientas, los equipos y las superficies de trabajo.
Control de vectores (insectos, roedores).
Eliminación o reducción al mínimo del material cortante o punzante.
Evitar que las trabajadoras embarazadas manipulen animales de riesgo (p.ej. rumiantes, roedores, aves) y productos de aborto.
Buenas prácticas de higiene: lavado de manos con agua y jabón al comenzar y finalizar la jornada laboral, después de quitarse los guantes y tras el contacto con elementos contaminados; evitar el contacto de las manos con los ojos, la nariz o la boca; evitar la exposición de heridas abiertas, cubriéndolas con apósitos estériles e impermeables. Utilización de ropa de trabajo y equipos de protección individual adecuados.
Precauciones en centros sanitarios
En el ámbito sanitario y veterinario se deberán adoptar las Precauciones Estándar (13).
EPI
Protección de las manos: guantes de protección frente a microorganismos (si es necesario, que solapen completamente con las mangas de la ropa de protección o de la ropa de trabajo), cuando sea inevitable el contacto directo con animales infectados o materiales infecciosos.
Protección respiratoria: mascarillas autofiltrantes tipo FFP2, preferiblemente FFP3, o máscaras con filtro P2 o P3 para operaciones en las que se generen bioaerosoles o polvo.
Protección ocular o facial: gafa de protección de montura universal en caso de riesgo de contacto accidental mano/guante contaminado-ojo, o pantalla de protección facial (símbolo de marcado en montura: 3) en caso de riesgo de exposición a salpicaduras, o gafa de protección de montura integral con hermeticidad frente a partículas (símbolo de marcado en montura: 4), en caso de riesgo de exposición a polvo.
Seguridad en laboratorio
Nivel de contención: 2
Los principales riesgos son la inoculación e ingesta accidental y el contacto con muestras o especímenes contaminados.
Las muestras o especímenes más peligrosos son la sangre, el líquido cefalorraquídeo, las heces, la placenta, el líquido amniótico, la sangre menstrual, los loquios, el meconio, las secreciones respiratorias, los aspirados gástricos, las lesiones dérmicas, el pus, los tejidos animales y los órganos infectados, como el cerebro y el hígado. También las muestras ambientales y de alimentos crudos (leche, vegetales, etc.).
Se requieren las prácticas y la contención de un nivel 2 de bioseguridad, tanto para las actividades de los laboratorios clínicos, como para los trabajos con cultivos y con animales de experimentación. Se debe evitar o reducir al mínimo el empleo de material cortante o punzante y trabajar dentro de una cabina de seguridad biológica en aquellas operaciones que impliquen manipular grandes volúmenes de muestra o concentraciones del agente, así como la generación de bioaerosoles, proyecciones o salpicaduras, además del uso de guantes de protección frente a microorganismos en caso de contacto con muestras contaminadas.
Bibliografía
- Heras C., García-Patos, V., Palacio, L., Bartralot, R., Mollet, J., Rodríguez, L., Pascual, C., Bodet, D., Tallada, N., Castells, A. Listeriosis neonatal. Actas Dermosifiliogr 2006;97:59-61 - Vol. 97 Núm.1.
- Janakiraman, V. Listeriosis in Pregnancy: Diagnosis, Treatment, and Prevention. Rev Obstet Gynecol. 2008 Fall; 1(4): 179–185.
- Agence nationale de sécurite sanitaire de l’alimentation de environnement et du travail (anses). Fiche de description de danger biologique transmissible par les aliments. Listeria monocytogenes. 2011.
- Centers for Disease Control and Prevention (CDC). Listeria (listeriosis). 2015
- Centers for Disease Control and Prevention (CDC). Biosafety in Microbiological and Biomedical Laboratories. 5th Edition. 2009.
- Fundación Vasca para la Seguridad Alimentaria. Listeria monocytogenes. 2006.
- Institut National de Recherche et de Sécurité (INRS). BAse d’OBservation des Agents Biologiques. Listeria monocytogenes. 2015.
- Instituto Nacional de Seguridad e Higiene en el Trabajo (INSHT). Directrices para la evaluación de riesgos y protección de la maternidad en el trabajo. 2011.
- Instituto Nacional de Seguridad y Salud en el Trabajo (INSST). Notas Técnicas de Prevención. NTP: 901.
- Ministerio de Sanidad, Servicios Sociales e Igualdad. Protocolos de Vigilancia Sanitaria Específica. AGENTES BIOLÓGICOS. Comisión de Salud Pública. Consejo Interterritorial del Sistema Nacional de Salud. 2001.
- Pan American Health Organization. Zoonoses and Communicable Diseases Common to Man and Animals, 3rd edition. Vol I. Bacterioses and mycoses. 2001.
- Public Health Agency of Canada. Pathogen Safety Data Sheets and Risk Assessment. Listeria monocytogenes. 2011.
- Servicio Riojano de Salud. Precauciones de aislamiento en centros sanitarios. 2008.
- The center for food security and public health; Iowa State University, Ames, IA, USA. Animal disease factsheets. Listeriosis. 2005.